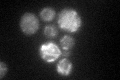
YJR051W
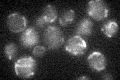
YJR051W

View description
Fumarate reductase, catalyzes the reduction of fumarate to succinate, required for the reoxidation of intracellular NADH under anaerobic conditions; mutations cause osmotic sensitivity
Localization:
Intensity:
Fold change:
Significance:
-
C’ GFP library in SD

mitochondria21.65 -
N' NOP1pr-GFP in SD

mitochondria64.819 -
N' TEF2pr-mCherry in SD

mitochondria105.348 -
N' NATIVEpr-GFP in SD

ER,punctate35.1222 -
N' TEF2pr-VC and Cyto-VN in SD

#N/A0 -
C’ GFP library in SD+DTT
mitochondria21.781No -
C’ GFP library in SD+H2O2

mitochondria17.990.83No -
C’ GFP library in Starvation Media
mitochondria22.181.02No -
C’ GFP library on the background of Pup2-DaMP

N/A -
C’ GFP library on the background of CCT mutant

N/A0N/AYes
